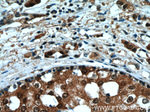
RAD23B Antibody in Immunohistochemistry (Paraffin) (IHC (P))

Search
Proteintech
RAD23B Polyclonal Antibody
{{$productOrderCtrl.translations['antibody.pdp.commerceCard.promotion.promotions']}}
{{$productOrderCtrl.translations['antibody.pdp.commerceCard.promotion.viewpromo']}}
{{$productOrderCtrl.translations['antibody.pdp.commerceCard.promotion.promocode']}}: {{promo.promoCode}} {{promo.promoTitle}} {{promo.promoDescription}}. {{$productOrderCtrl.translations['antibody.pdp.commerceCard.promotion.learnmore']}}
产品信息
12121-1-AP
种属反应
已发表种属
宿主/亚型
分类
类型
抗原
偶联物
形式
浓度
规格
纯化类型
保存液
内含物
保存条件
运输条件
产品详细信息
Immunogen sequence: MQVTLKTLQ QQTFKIDIDP EETVKALKEK IESEKGKDAF PVAGQKLIYA GKILNDDTAL KEYKIDEKNF VVVMVTKPKA VSTPAPATTQ QSAPASTTAV TSSTTTTVAQ APTPVPALAP TSTPASITPA SATASSEPAP ASAAKQEKPA EKPAETPVAT SPTATDSTSG DSSRSNLFED ATSALVTGQS YENMVTEIMS MGYEREQVIA ALRASFNNPD RAVEYLLMGI PGDRESQAVV DPPQAASTGV PQSSAVAAAA ATTTATTTTT SSGGHPLEFL RNQPQFQQMR QIIQQNPSLL PALLQQIGRE NPQLLQQISQ HQEHFIQMLN EPVQEAGGQG GGGGGGSGGI AEAGSGHMNY IQVTPQEKEA IERLKALGFP EGLVIQAYFA CEKNENLAAN FLLQQNFDED (1-409 aa encoded by BC020973)
靶标信息
The protein encoded by this gene is one of two human homologs of Saccharomyces cerevisiae Rad23, a protein involved in the nucleotide excision repair (NER). This protein was found to be a component of the protein complex that specifically complements the NER defect of xeroderma pigmentosum group C (XP-c) cell extracts in vitro. This protein was also shown to interact with, and elevate the nucleotide excision activity of 3-methyladenine-DNA glycosylase (MPG), which suggested a role in DNA damage recognition in base excision repair. This protein contains an N-terminal ubiquitin-like domain, which was reported to interact with 26S proteasome, and thus this protein may be involved in the ubiquitin mediated proteolytic pathway in cells.
仅用于科研。不用于诊断过程。未经明确授权不得转售。
生物信息学
蛋白别名: HR23B; Lysine-specific demethylase RAD23B; p58; RAD23, yeast homolog of, B; RAD23b homolog; RAD23B; alternatively spliced; unnamed protein product; UV excision repair protein RAD23 homolog B; XP-C repair complementing complex 58 kDa; XP-C repair complementing protein; XP-C repair-complementing complex 58 kDa protein
基因别名: 0610007D13Rik; AV001138; HHR23B; HR23B; Mhr23b; P58; RAD23B
UniProt ID: (Human) P54727, (Mouse) P54728, (Rat) Q4KMA2
Entrez Gene ID: (Human) 5887, (Mouse) 19359, (Rat) 298012